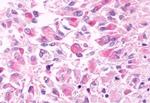
GPR81 Antibody in Immunohistochemistry (Paraffin) (IHC (P))
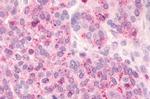
GPR81 Antibody in Immunohistochemistry (Paraffin) (IHC (P))

Search
Invitrogen
GPR81 Polyclonal Antibody
{{$productOrderCtrl.translations['antibody.pdp.commerceCard.promotion.promotions']}}
{{$productOrderCtrl.translations['antibody.pdp.commerceCard.promotion.viewpromo']}}
{{$productOrderCtrl.translations['antibody.pdp.commerceCard.promotion.promocode']}}: {{promo.promoCode}} {{promo.promoTitle}} {{promo.promoDescription}}. {{$productOrderCtrl.translations['antibody.pdp.commerceCard.promotion.learnmore']}}
产品信息
PA1-20523
宿主/亚型
分类
类型
抗原
偶联物
形式
浓度
规格
保存条件
运输条件
RRID
产品详细信息
PA1-20523 detects G Protein-Coupled Receptor GPR81 in human samples.
PA1-20523 has been successfully used in immunohistochemistry (paraffin) procedures.
The PA1-20523 immunogen is a synthetic peptide corresponding to the 2nd extracellular loop of human G Protein-Coupled Receptor GPR81.
靶标信息
The G protein-coupled receptor GPCR GPR81 has been reported primarily in adipose and pituitary. ESTs have been isolated from human bladder cancer and colon cancer libraries. It has not been detected in frontal, temporal and occipital lobes of the cortex, basal forebrain, caudate nucleus, nucleus accumbens, and hippocampus.
仅用于科研。不用于诊断过程。未经明确授权不得转售。